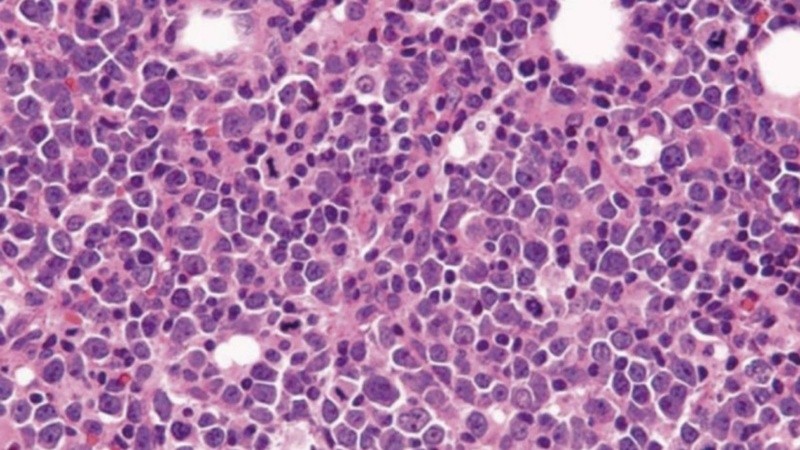
Tiene mayor frecuencia en varones mayores de 60 años y se caracteriza por una alteración genética específica.

El llamado "linfomas de células del manto" es un tipo de cáncer hematológico que se caracteriza por su agresividad. Originado en las células B del sistema linfático, muchas veces es diagnosticado en estadios avanzados por su similitud con otros cuadros. Por este motivo, desde la Asociación Civil Linfomas Argentina (ACLA) buscan que el mismo tenga una mayor visibilidad en la agenda pública.
Desde la asociación indicaron que, aunque representa el 5% de los casos de linfoma, eso se traduce en cerca de 450 casos por año en Argentina: “Se da con mayor frecuencia en varones mayores de 60 años y se caracteriza por una alteración genética específica, que desencadena una proliferación celular descontrolada y puede afectar no solo a los ganglios linfáticos, sino también a otros órganos como la médula ósea, el bazo, el hígado, el tracto gastrointestinal, la piel, los pulmones y el sistema nervioso central”.
Quienes padecen este tipo de cáncer pueden presentar pérdida de apetito y peso, fiebre, sudores nocturnos, náuseas y/o vómitos, indigestión, dolor o distensión abdominal, sensación de saciedad o molestias a raíz del agrandamiento de las amígdalas, el hígado o el bazo, presión o dolor en la zona lumbar que puede extenderse hacia una o ambas piernas, o fatiga a causa de la anemia.
El problema, según explican los especialistas, es que en sus primeras etapas puede pasar inadvertido porque algunos de los síntomas que podrían indicar la presencia de este tipo de linfoma pueden confundirse con otras afecciones más comunes. En muchos casos, el diagnóstico llega cuando la enfermedad ya comprometió varios órganos y se requiere un tratamiento intensivo.
Para llegar al diagnóstico, partiendo de la evaluación clínica y de la sintomatología del paciente, la confirmación se da mediante estudios específicos que debe solicitar el profesional de la salud: “Es importante prestar atención a los síntomas, no subestimar cambios persistentes en el cuerpo y consultar al médico ante la presencia de signos sospechosos. Conocer la existencia de este tipo de linfoma, aunque poco frecuente, puede marcar la diferencia entre un diagnóstico temprano y una enfermedad avanzada”.
El tratamiento
Para determinar el tratamiento más conveniente, el equipo médico (liderado por un oncohematólogo) considerará la edad, el estado general de salud y funcional del paciente, además de algunos parámetros de estudios de laboratorio como el nivel de deshidrogenasa láctica y el conteo de glóbulos blancos.
Según dicho perfil, el linfoma del manto puede tratarse con quimioterapia, anticuerpos monoclonales o terapias dirigidas de administración oral, con mejor perfil de seguridad, tasas de respuesta más elevadas y la posibilidad de controlar la enfermedad por más tiempo.
“Estamos viendo un cambio de paradigma en el tratamiento de esta enfermedad. Aun así, es frecuente que los pacientes desarrollen recaídas, por lo que es una buena noticia que cada vez haya más y mejores herramientas para su abordaje, para que podamos ofrecerles a los pacientes diferentes opciones en el camino con su enfermedad”, sostuvieron.
En tal sentido, "el acceso al diagnóstico, a profesionales capacitados y a tratamientos innovadores debe ser una prioridad para garantizar la equidad en la atención oncológica”.
Fuente: NA.